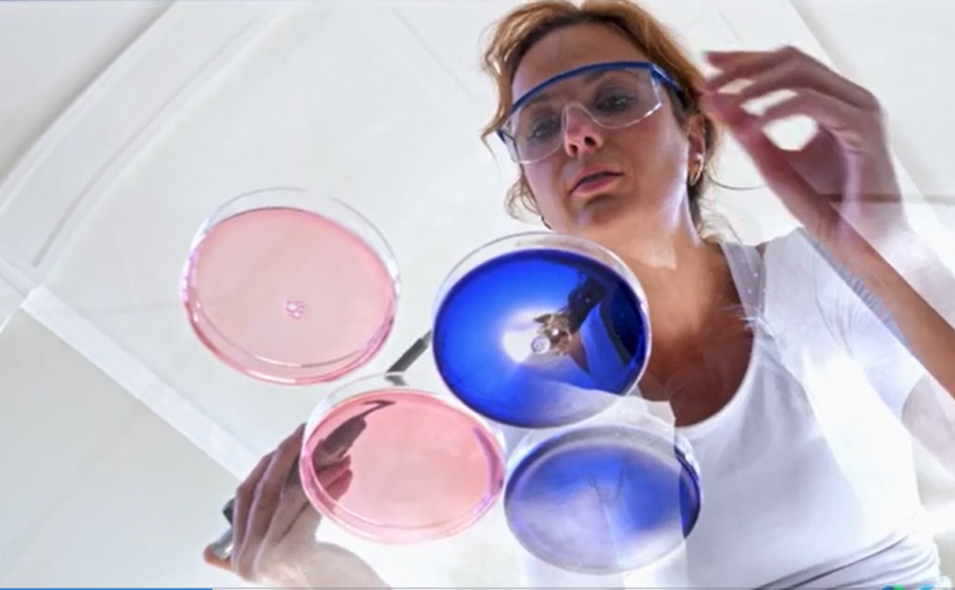

Engineered for savings, driven by discovery
Avantor and BIO extend BIO Business Solutions partnership for five years.

EQUIP – La puissance et la précision au service de votre laboratoire
Des économies sans compromis – retrouvez vos marques préférées à prix mini, la qualité en plus !

Perfectly paired to optimize your harvest process, sustainably
NEW! J.T.Baker Cell Lysis and Endonuclease work better together to scale up your gene therapy process.

The right mix of quality and precision
Versatile open and closed systems engineered to meet your powder and liquid needs

Get the high-quality solvents you need
Check out our featured solvents today

The Lab of the Future is here
Explore innovation in action

Precision that powers purity
Discover uncompromising quality for every analytical chemistry workflow
Solutions supporting your scientific journey
Des économies sans compromis – retrouvez vos marques préférées à prix mini, la qualité en plus !
Featuring a unique aerosol barrier and available in a number of speciality and packaging formats, Thermo Scientific™ ART™ Universal Pipette Tips meet the needs of every lab.
Every dataset holds more than images—it holds answers. The new ImageXpress HCS.ai High-Content Screening System goes beyond data capture, delivering high-speed acquisition, AI-powered analysis, and advanced imaging to turn complex data into discoveries.
Discover streamlined sequencing workflows for reference-quality microbial genomes — ideal for outbreak detection, microbial evolution, food safety and clinical research.
Choose from three distinct performance levels, making it easy to select the right vial or wellplate for your instrument, application, and budget.
Discover the key focus columns from the Merck Supelco range to suit all of your chromatography analysis needs.
Get high sample recovery with Amicon® Ultra centrifugal ultrafiltration devices for fast and efficient protein and antibody concentration.
Innovation at Avantor
In the race to treat and cure disease, there is no room for error, and no time for delays. See our commitment to cell & gene therapy production in action.
Highlights
See how we’re expanding our legacy, five years after becoming a public company.
Featured content
A holistic view of viral vector manufacturing for gene therapies.
Advancing the molecule to production.